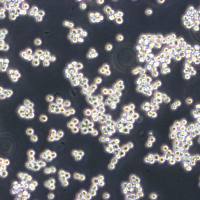
MDA-kb2 Cells人乳腺癌细胞库复苏传代|STR图谱

相关产品推荐更多 >
万千商家帮你免费找货
0 人在求购买到急需产品
- 详细信息
- 文献和实验
- 技术资料
- 品系:
详见细胞说明资料
- 细胞类型:
详见细胞说明资料
- 肿瘤类型:
详见细胞说明资料
- 供应商:
上海冠导生物工程有限公司
- 库存:
≥100瓶
- 生长状态:
详见细胞说明资料
- 年限:
详见细胞说明资料
- 运输方式:
常温运输【复苏细胞】或干冰运输【冻存细胞】
- 器官来源:
详见细胞说明资料
- 是否是肿瘤细胞:
详见细胞说明资料
- 细胞形态:
详见细胞说明资料
- 免疫类型:
详见细胞说明资料
- 物种来源:
详见细胞说明资料
- 相关疾病:
详见细胞说明资料
- 组织来源:
详见细胞说明资料
- 英文名:
NCI-H2452[H2452]人间皮瘤传代细胞种子库|送STR图谱
- 规格:
1*10(6)Cellls/瓶
"NCI-H2452[H2452]人间皮瘤传代细胞种子库|送STR图谱
传代方法:1:2-1:4(首次传代建议1:2)
生长特性:贴壁生长
换液频率:每周2-3次
背景资料:详见相关文献介绍
细胞培养实验中常见问题总结:1)一般客户拿到细胞后,应该注意什么?客户收到细胞后先不开盖,放在培养箱静置若干小时后(看细胞密度而定)在倒置显微镜下观察细胞生长情况,并对细胞进行不同倍数拍照(建议受收细胞后观察培养基的颜色和是否有漏情况,显微镜下拍细胞100X,200X各一张),排除细胞本身污染的情况;收到细胞未开封,出现污染状况我们负责免费发送一株细胞。收到细胞时如无异常情况,请在显微镜下观察细胞密度,如为贴壁细胞,未超过80%汇合度时,将培养瓶中培养吸出,留下10ml培养继续培养;超过80%汇合度时,请按细胞培养条件传代培养。如为悬浮细胞,吸出培养、1000转/分钟离心2分钟,吸出上清,管底细胞用新鲜培养基悬浮细胞后移回培养瓶。细胞消化建议使用PBS配制,慎用Hanks配制;2)快递细胞多久能到,是寄冻存的细胞还是复苏HAO的细胞?我们采用快递发货,一般外地2--3天,寄细胞前请确认当地温度,如果气温低于4度的,则采用邮寄冻存细胞;3)可否使用与原先培养条件不同之培养基?不能。每一细胞株均有其定使用且已适应之细胞培养基,若骤然使用和原先提供之培养条件不同之培养基,细胞大都无法立即适应,造成细胞无法存活;4)可否使用与原先培养条件不同之血清种类?不能。血清是细胞培养上一个为重要的营养来源,所以血清的种类和品质对于细胞的生长会产生大的影响。来自不同物种的血清,在一些物质或分子的量或内容物上都有所不同,血清使用错误常会造成细胞无法存活。
H1836 Cells;背景说明:详见相关文献介绍;传代方法:每周换液2-3次。;生长特性:悬浮生长;形态特性:详见产品说明;相关产品有:H-1581 Cells、MUGCHOR1 Cells、GM00215A Cells
FDCP1 Cells;背景说明:详见相关文献介绍;传代方法:2-3天换液1次;生长特性:悬浮生长;形态特性:淋巴母细胞;相关产品有:RT4P Cells、CCRF/CEM Cells、COR-L23 Cells
231-luc Cells;背景说明:详见相关文献介绍;传代方法:1:2传代;生长特性:贴壁或悬浮,详见产品说明部分;形态特性:详见产品说明;相关产品有:BTT739 Cells、HCC-2185 Cells、RPE1-hTERT Cells
┈订┈购┈热┈线:1┈5┈8┈0┈0┈5┈7┈6┈8┈6┈7【微信同号】┈Q┈Q:3┈3┈0┈7┈2┈0┈4┈2┈7┈1;
NCI-H2452[H2452]人间皮瘤传代细胞种子库|送STR图谱
产品包装形式:复苏细胞:T25培养瓶(一瓶)或冻存细胞:1ml冻存管(两支)
来源说明:细胞主要来源ATCC、DSMZ等细胞库
物种来源:Human\Mouse\Rat\Others
IOSE-80 Cells;背景说明:卵巢;上皮细胞;SV40转化;女性;传代方法:1:2-1:3传代;每周换液2-3次。;生长特性:贴壁;形态特性:详见产品说明;相关产品有:mouse Inner Medullary Collecting Duct-3 Cells、LO2 Cells、H1781 Cells
198 Cells(拥有STR基因鉴定图谱)
870 Cells;背景说明:儿童急性髓系白血病;传代方法:1:2-1:3传代;每周换液2-3次。;生长特性:悬浮;形态特性:详见产品说明;相关产品有:H1650 Cells、BTI-Tn5B14 Cells、EFO 27 Cells
OP9 Cells;背景说明:骨髓基质;C57BL/6 x C3H;传代方法:1:2-1:3传代;每周换液2-3次。;生长特性:贴壁;形态特性:详见产品说明;相关产品有:SNU354 Cells、P3X63 Ag8 Cells、HCC-1187 Cells
形态特性:上皮细胞样
NCI-H2452[H2452]人间皮瘤传代细胞种子库|送STR图谱
贴壁细胞(adherent cells):该类细胞的生长必须有可以贴附的支持物表面,细胞依靠自身分泌的或培养基中提供的贴附因子才能在该表面上生长,繁殖;当细胞在该表面生长后,一般形成两种形态,即成纤维样细胞性或上皮样细胞;其生长过程分为游离期、贴壁期、潜伏期、对数期、平台期和衰退期。悬浮细胞(suspension cell):不贴附于生长物,细胞呈圆形,呈单个细胞或者细小细胞团,悬浮细胞生长空间大,传代方便,能够大量增殖。
┈订┈购┈热┈线:1┈5┈8┈0┈0┈5┈7┈6┈8┈6┈7【微信同号】┈Q┈Q:3┈3┈0┈7┈2┈0┈4┈2┈7┈1;
上皮细胞(epithelial cell)是构成上皮组织的基本单位,广泛分布在人体的各个表面和体腔内,外胚层来源:皮肤、腺垂体、内耳膜、角膜、晶状体、鼻腔、口腔、肛门等处的上皮细胞由外胚层发育而来。中胚层来源:间皮、内皮等上皮细胞由中胚层发育而来。内胚层来源:中耳、呼吸道、肺、胸腺、消化道、消化腺、膀胱、阴道、甲状腺、甲状旁腺等处的上皮细胞由内胚层发育而来。许多癌症起源于上皮细胞,如肝细胞癌、结直肠癌、乳腺癌、肺癌、胃癌、前列腺癌、卵巢癌和子宫内膜癌。这些癌症中的上皮细胞通常表现出细胞标志物的变化,如E-cadherin的缺失和N-cadherin、vimentin等间充质细胞标志物的表达上调。
RPMI 8402 Cells;背景说明:急性T淋巴细胞白血病;女性;传代方法:1:2-1:3传代;每周换液2-3次。;生长特性:悬浮;形态特性:详见产品说明;相关产品有:Hs-611-T Cells、AML-2 Cells、HT-1197 Cells
SKLU01 Cells;背景说明:该细胞系源于一位60岁的白人女性患者的肺腺癌组织。;传代方法:1:2传代;每周换液2次。;生长特性:贴壁生长;形态特性:上皮细胞样;相关产品有:WM 239 Cells、MM-1S Cells、ATDC-5 Cells
YAC-1 Cells;背景说明:YAC-1源自Mo-MuLV诱导的A/Sn小鼠淋巴瘤。细胞对NK细胞的作用敏感,可用于NK细胞活性检测。鼠痘病毒阴性。;传代方法:1:2传代;生长特性:悬浮生长;形态特性:淋巴母细胞样;相关产品有:THLE-3 Cells、Hu-P-T3 Cells、THP 1 Cells
SKCol1 Cells;背景说明:该细胞来源于结直肠病人的转移性腹水。;传代方法:1:2-1:3传代,每周2-3次。;生长特性:贴壁生长;形态特性:上皮细胞样;相关产品有:AtT 20 Cells、NCIH250 Cells、OVCAR-8/ADR Cells
EOL1 Cells;背景说明:急性髓系白血病;男性;传代方法:1:2-1:3传代;每周换液2-3次。;生长特性:悬浮;形态特性:详见产品说明;相关产品有:H-2126 Cells、NCI-SNU-475 Cells、CMT.64 Cells
HM Cells;背景说明:小神经胶质 Cells;传代方法:1:2-1:3传代;每周换液2-3次。;生长特性:贴壁;形态特性:详见产品说明;相关产品有:HCC1143 Cells、P388D1 Cells、SK-Mel 1 Cells
SBC-5 Cells;背景说明:详见相关文献介绍;传代方法:每周换液2-3次。;生长特性:贴壁或悬浮,详见产品说明部分;形态特性:详见产品说明;相关产品有:SACC-LM Cells、Soleus clone 8 Cells、253J-Bladder-V Cells
ARO-81 Cells;背景说明:甲状腺癌;女性;传代方法:1:2-1:3传代;每周换液2-3次。;生长特性:贴壁;形态特性:详见产品说明;相关产品有:CT-26 Cells、RCC4 Cells、SK-N-BE(1) Cells
NCIH146 Cells;背景说明:详见相关文献介绍;传代方法:1:2—1:6传代,每周换液2-3次;生长特性:悬浮生长;形态特性:上皮细胞;相关产品有:NCI-H64 Cells、A375SM Cells、293-F Cells
MDAMB468 Cells;背景说明:该细胞是1977年由CailleauR等从一位患有转移性乳腺癌的51岁黑人女性的胸腔积液中分离得到的。虽然供体组织的G6PD等位基因杂合,但此细胞株始终表现为G6PDA表型。P53基因273位密码子存在G→A突变,从而导致Arg→His替代。每个细胞上存在1×106个EGF受体。;传代方法:1:2-1:4传代;2-3天换液1次;生长特性:贴壁生长;形态特性:上皮样;相关产品有:HT1080 Cells、BC-023 Cells、IM9 Cells
Mink Lung Cells;背景说明:详见相关文献介绍;传代方法:1:2-1:3传代;每周换液2-3次。;生长特性:贴壁或悬浮,详见产品说明部分;形态特性:详见产品说明;相关产品有:NCI-H1915 Cells、HCC-44 Cells、LNCaP clone FGC Cells
HRVEC Cells;背景说明:视网膜微血管;内皮 Cells;传代方法:1:2-1:3传代;每周换液2-3次。;生长特性:贴壁;形态特性:详见产品说明;相关产品有:CCK-81 Cells、COLO_320DM Cells、L-6 Cells
HeLa 229 Cells;背景说明:宫颈癌;女性;传代方法:1:2-1:3传代;每周换液2-3次。;生长特性:贴壁;形态特性:详见产品说明;相关产品有:NTERA-2cl.D1 Cells、LS 180 Cells、FRTL5 Cells
GRSL Cells;背景说明:详见相关文献介绍;传代方法:1:2-1:3传代;每周换液2-3次。;生长特性:贴壁或悬浮,详见产品说明部分;形态特性:详见产品说明;相关产品有:Granta519 Cells、DBTRG-05MG Cells、NCI-H1836 Cells
H-1395 Cells;背景说明:详见相关文献介绍;传代方法:1:2传代;5-6天传代一次。;生长特性:贴壁生长;形态特性:上皮样;多角形;相关产品有:A549-Taxol Cells、NCI-322 Cells、UO-31 Cells
DU-145 Cells;背景说明:DU 145 是从一位有3年淋巴细胞白血病史的前列腺癌患者的脑部转移灶中建立的。该细胞系未检测到激素敏感性,酸性酶阳性,单个的细胞可在软琼脂中形成集落。对此细胞和原始肿瘤的亚显微结构分析可见微绒毛、微丝、细胞桥粒、线粒体、发达的高尔基体和异质溶酶体。该细胞不表达前列腺抗原。;传代方法:1:2-1:3传代;每周换液2-3次。;生长特性:贴壁;形态特性:上皮细胞样;相关产品有:HRGEC Cells、Human Pancreatic Duct Epithelial Cells、Hx-147 Cells
DSL-6A-C1 Cells;背景说明:胰腺癌;雄性;Lewis;传代方法:1:2-1:3传代;每周换液2-3次。;生长特性:贴壁;形态特性:详见产品说明;相关产品有:HTh 74 Cells、SW-1271 Cells、HMEC Cells
Abcam A-549 BRD3 KO Cells(拥有STR基因鉴定图谱)
Abcam Raji TAPBP KO Cells(拥有STR基因鉴定图谱)
BayGenomics ES cell line BGB615 Cells(拥有STR基因鉴定图谱)
BayGenomics ES cell line RRS102 Cells(拥有STR基因鉴定图谱)
BayGenomics ES cell line YTA363 Cells(拥有STR基因鉴定图谱)
CHDIi055-A Cells(拥有STR基因鉴定图谱)
DA01870 Cells(拥有STR基因鉴定图谱)
DA05242 Cells(拥有STR基因鉴定图谱)
GE6 Cells(拥有STR基因鉴定图谱)
SW 1271 Cells;背景说明:详见相关文献介绍;传代方法:1:2-1:3传代;每周换液2-3次。;生长特性:贴壁或悬浮,详见产品说明部分;形态特性:详见产品说明;相关产品有:J774 A1 Cells、T-T Cells、COLO-699 Cells
RH-30 Cells;背景说明:肺泡横纹肌肉瘤;骨髓转移;传代方法:1:2-1:3传代;每周换液2-3次。;生长特性:贴壁;形态特性:详见产品说明;相关产品有:IAR-20 Cells、SK-N-BE2C Cells、CMT 93 Cells
Hopkins-92 Cells;背景说明:详见相关文献介绍;传代方法:1:2-1:3传代;每周换液2-3次。;生长特性:贴壁或悬浮,详见产品说明部分;形态特性:详见产品说明;相关产品有:SKBr3 Cells、H1650 Cells、Panc 4.03 Cells
SNU449 Cells;背景说明:详见相关文献介绍;传代方法:1:5-1:10传代;每周2-3次;生长特性:贴壁生长;形态特性:上皮样;多角形;相关产品有:BNL 1MEA.7R.1 Cells、NCI-H1975 Cells、HUC-1 Cells
L929(NCTC) Cells;背景说明:详见相关文献介绍;传代方法:1:2-1:3传代;每周换液2-3次。;生长特性:贴壁或悬浮,详见产品说明部分;形态特性:详见产品说明;相关产品有:C-26 Cells、GP-293 Cells、AHH1 Cells
B-104 Cells;背景说明:神经母细胞瘤;BDIX;传代方法:1:2-1:3传代;每周换液2-3次。;生长特性:贴壁;形态特性:详见产品说明;相关产品有:COLO-320DM Cells、SaOS Cells、RMS 13 Cells
TC-1[JHU-1] Cells;背景说明:详见相关文献介绍;传代方法:1:2传代;生长特性:贴壁生长 ;形态特性:详见产品说明;相关产品有:OCI/AML5 Cells、BEL/FU Cells、MLA 144 Cells
HSC-4 Cells;背景说明:详见相关文献介绍;传代方法:1 x 10^5 cells/10cm dish;生长特性:贴壁生长;形态特性:上皮细胞;相关产品有:RPMC Cells、COLO 679 Cells、SK-N-BE Cells
NCI-446 Cells;背景说明:该细胞是1982年由CarneyD和GazdarAF等从一位小细胞肺癌患者的胸腔积液中建立的。细胞的原始形态并不具有小细胞肺癌特征。这个细胞株是小细胞肺癌的生化和形态学上的变种,表达神经元特有的烯醇酶和脑型肌酸激酶同工酶;左旋多巴脱羧酶、蚕素、抗利尿激素、催产素或胃泌激素释放肽未达到可检测水平。与正常细胞相比,该细胞c-mycDNA序列扩增约20倍,RNA增加15倍。最初传代培养基用含有5%FBS的RPMI1640,另外添加10nM化可的松、0.005mg/ml胰岛素、0.01mg/ml转铁;传代方法:1:2传代;生长特性:贴壁/悬浮生长,混合;形态特性:上皮样;相关产品有:RM1 Cells、H1522 Cells、Intestinal Porcine Epithelial Cell line-1 Cells
COLO-679 Cells;背景说明:详见相关文献介绍;传代方法:1:2传代;生长特性:贴壁生长 ;形态特性:详见产品说明;相关产品有:TE-6 Cells、H283 Cells、3T3-442A Cells
NCI-H1385 Cells;背景说明:详见相关文献介绍;传代方法:1:2-1:3传代;每周换液2-3次。;生长特性:贴壁或悬浮,详见产品说明部分;形态特性:详见产品说明;相关产品有:TCCSUP Cells、H1703 Cells、LYR Cells
NCI-H2452[H2452]人间皮瘤传代细胞种子库|送STR图谱
Mia PACA 2 Cells;背景说明:详见相关文献介绍;传代方法:1:2传代;;生长特性:贴壁生长;形态特性:详见产品说明;相关产品有:U118 Cells、Ramos 1 Cells、GM06141B Cells
JVM3 Cells;背景说明:慢性髓白血病;女性;传代方法:1:2-1:3传代;每周换液2-3次。;生长特性:悬浮;形态特性:详见产品说明;相关产品有:NCI-SNU-761 Cells、MDA-MB-231 Cells、SH-SY5Y Cells
JVM3 Cells;背景说明:慢性髓白血病;女性;传代方法:1:2-1:3传代;每周换液2-3次。;生长特性:悬浮;形态特性:详见产品说明;相关产品有:NCI-SNU-761 Cells、MDA-MB-231 Cells、SH-SY5Y Cells
CA46 Cells;背景说明:该细胞源自Burkitt's淋巴瘤患者的B淋巴细胞,EBNA、Fc阴性。;传代方法:1:2传代;生长特性:悬浮生长;形态特性:淋巴母细胞样;相关产品有:H-69 Cells、C22 (Clara) Cells、Kasumi-6 Cells
GM20018 Cells(拥有STR基因鉴定图谱)
HAP1 IRF3 (-) 2 Cells(拥有STR基因鉴定图谱)
C3H10T1/2 clone8 Cells;背景说明:详见相关文献介绍;传代方法:1:2-1:3传代;每周换液2-3次。;生长特性:贴壁或悬浮,详见产品说明部分;形态特性:详见产品说明;相关产品有:COS-1 Cells、MCF10A Cells、NCIH322 Cells
JROECL19 Cells;背景说明:详见相关文献介绍;传代方法:1:2传代;生长特性:贴壁生长;形态特性:上皮样;相关产品有:LC1/Sq Cells、U118 Cells、BT483 Cells
FU-OV-1 Cells;背景说明:详见相关文献介绍;传代方法:1:2-1:3传代;每周换液2-3次。;生长特性:贴壁或悬浮,详见产品说明部分;形态特性:详见产品说明;相关产品有:NCIH526 Cells、MDA-MB-231-GFP Cells、U-CH1 Cells
UCLA-SO-M20 Cells;背景说明:黑色素瘤;传代方法:1:2-1:3传代;每周换液2-3次。;生长特性:贴壁;形态特性:详见产品说明;相关产品有:HCC-2935 Cells、Henrietta Lacks cells Cells、BC-3H-1 Cells
639V Cells;背景说明:膀胱癌;男性;传代方法:1:2-1:3传代;每周换液2-3次。;生长特性:贴壁;形态特性:详见产品说明;相关产品有:Hs695T Cells、OPM2 Cells、SUDHL-4 Cells
HRVEC Cells;背景说明:视网膜微血管;内皮 Cells;传代方法:1:2-1:3传代;每周换液2-3次。;生长特性:贴壁;形态特性:详见产品说明;相关产品有:CCK-81 Cells、COLO_320DM Cells、L-6 Cells
COLO-205 Cells;背景说明:该细胞系是1957年由T.U.Sample等从患有结肠癌的70岁男性白人的腹水中分离的。该病人在取腹水样品前已用5-尿嘧啶治疗4~6周。角蛋白免疫过氧化物酶染色阳性;产生CEA、IL10。;传代方法:1:2传代;生长特性:贴壁生长;形态特性:上皮样;相关产品有:NCI-H1105 Cells、COV 434 Cells、NMCG-1 Cells
AM Cells;背景说明:详见相关文献介绍;传代方法:1:2传代;生长特性:贴壁生长;形态特性:上皮细胞;相关产品有:HFLS-RA Cells、GLC-15 Cells、HO1N1 Cells
HPS0953 Cells(拥有STR基因鉴定图谱)
Josh 5 Cells(拥有STR基因鉴定图谱)
MDCC-JMV-1 Cells(拥有STR基因鉴定图谱)
ND41865 Cells(拥有STR基因鉴定图谱)
PSFLBV084 Cells(拥有STR基因鉴定图谱)
U2OS GFP-TUBA1B Cells(拥有STR基因鉴定图谱)
UMCGi007-A Cells(拥有STR基因鉴定图谱)
HEV0117 Cells(拥有STR基因鉴定图谱)
Mesothelial cells transfected with pRSV-T 5A Cells;背景说明:详见相关文献介绍;传代方法:1:2传代;生长特性:贴壁生长;形态特性:详见产品说明;相关产品有:H128 Cells、HASMC Cells、NCI-H1299 Cells
COV-362 Cells;背景说明:详见相关文献介绍;传代方法:1:2传代;生长特性:贴壁生长;形态特性:上皮细胞;相关产品有:BAEC Cells、MKN45 Cells、PLB 985 Cells
Det. 562 Cells;背景说明:器官:咽头 疾病:癌 取材转移灶:胸水;传代方法:1:2-1:4传代,2-3天换液1次。;生长特性:贴壁生长;形态特性:上皮细胞;相关产品有:H19-7 Cells、SNU620 Cells、MES 13 Cells
MT-2 Cells;背景说明:详见相关文献介绍;传代方法:1:2-1:3传代;生长特性:悬浮生长;形态特性:淋巴母细胞;相关产品有:Stanford University-Diffuse Histiocytic Lymphoma-16 Cells、SKNO-1 Cells、RPTEC TERT1 Cells
SKMEL2 Cells;背景说明:详见相关文献介绍;传代方法:1:3-1:6传代,2-3天换液1次。;生长特性:贴壁生长;形态特性:多边形的;相关产品有:Tca-83 Cells、SW1353 Cells、GM04679 Cells
SKMEL2 Cells;背景说明:详见相关文献介绍;传代方法:1:3-1:6传代,2-3天换液1次。;生长特性:贴壁生长;形态特性:多边形的;相关产品有:Tca-83 Cells、SW1353 Cells、GM04679 Cells
HCC-94 Cells;背景说明:详见相关文献介绍;传代方法:1:2-1:3传代;每周换液2-3次。;生长特性:贴壁或悬浮,详见产品说明部分;形态特性:详见产品说明;相关产品有:RPE D407 Cells、8226/S Cells、H2081 Cells
TFK-1 Cells;背景说明:胆管癌;男性;传代方法:1:2-1:3传代;每周换液2-3次。;生长特性:贴壁;形态特性:详见产品说明;相关产品有:PNT1A Cells、MES-SA-Dx5 Cells、MDA PCa 2b Cells
OB2 Cells;背景说明:详见相关文献介绍;传代方法:每周2-3次。;生长特性:悬浮生长;形态特性:淋巴母细胞;相关产品有:Lieming Xu-2 Cells、OCI/AML4 Cells、A2780 Cells
SUDHL16 Cells;背景说明:详见相关文献介绍;传代方法:1:2-1:3传代;每周换液2-3次。;生长特性:贴壁或悬浮,详见产品说明部分;形态特性:详见产品说明;相关产品有:NK92-MI Cells、ARO81-1 Cells、NCIH146 Cells
SK-MEL 28 Cells;背景说明:详见相关文献介绍;传代方法:1:3-1:8传代,2-3天换液1次。;生长特性:贴壁生长;形态特性:星形的;相关产品有:NS1-Ag4 Cells、OSC19 Cells、IHC-ST1 Cells
SK-GT-4 Cells;背景说明:详见相关文献介绍;传代方法:1:2-1:3传代;每周换液2-3次。;生长特性:贴壁或悬浮,详见产品说明部分;形态特性:详见产品说明;相关产品有:6-10B Cells、H1963 Cells、M2-10B4 Cells
T. T Cells;背景说明:详见相关文献介绍;传代方法:10^5 cells/60mm dish;生长特性:贴壁生长;形态特性:上皮细胞样;相关产品有:Experimental Mammary Tumour-6 Cells、FDC-P1 Cells、HSC-5 [Human skin squamous cell carcinoma] Cells
NCI-H2452[H2452]人间皮瘤传代细胞种子库|送STR图谱
NPC-TW 039 Cells;背景说明:鼻咽癌;传代方法:1:2-1:3传代;每周换液2-3次。;生长特性:贴壁;形态特性:详见产品说明;相关产品有:Leghorn Male Hepatoma cell line Cells、LLC PK1 Cells、CAL51 Cells
WRL 68 Cells;背景说明:胚胎;肝 Cells;传代方法:1:2-1:3传代;每周换液2-3次。;生长特性:贴壁;形态特性:详见产品说明;相关产品有:RAT2 Cells、LIXC002 Cells、U 138 MG Cells
SN-56/OBR Cells(拥有STR基因鉴定图谱)
SUM-190 Cells;背景说明:乳腺癌;女性;传代方法:1:2-1:3传代;每周换液2-3次。;生长特性:贴壁;形态特性:详见产品说明;相关产品有:NCI-H1355 Cells、FL62891 Cells、Oka-C1 Cells
P3-X63-Ag 8.653 Cells;背景说明:详见相关文献介绍;传代方法:1:2-1:3传代;每周换液2-3次。;生长特性:贴壁或悬浮,详见产品说明部分;形态特性:详见产品说明;相关产品有:NCIH1618 Cells、NBLS Cells、TGW Cells
RM1 Cells;背景说明:前列腺癌;C57BL/6;传代方法:1:2-1:3传代;每周换液2-3次。;生长特性:贴壁;形态特性:详见产品说明;相关产品有:NCIH208 Cells、RAMSCs Cells、CFPAC-1 Cells
M.D. Anderson-Prostate Cancer-2b Cells;背景说明:详见相关文献介绍;传代方法:1:2-1:4传代,2-3天换液1次。;生长特性:贴壁生长;形态特性:上皮细胞;相关产品有:1E8-H Cells、H548 Cells、Panc-03.27 Cells
H-2073 Cells;背景说明:详见相关文献介绍;传代方法:1:3-1:6传代 ;生长特性:贴壁生长;形态特性:上皮细胞;相关产品有:Sf21 Cells、KMB17 Cells、Huh-7 Cells
P3-Jiyoye Cells;背景说明:详见相关文献介绍;传代方法:每周2-3次。;生长特性:悬浮生长;形态特性:淋巴母细胞;相关产品有:M-NFS-60 Cells、SHZ-88 Cells、SK-RC-39 Cells
LIPF178C Cells;背景说明:胆管癌;传代方法:1:2-1:3传代;每周换液2-3次。;生长特性:贴壁;形态特性:详见产品说明;相关产品有:NEC8 Cells、GM04154 Cells、C41 Cells
Normal Rat Kidney-52E Cells;背景说明:详见相关文献介绍;传代方法:1:2传代;生长特性:贴壁生长;形态特性:上皮细胞样;相关产品有:U-138-MG Cells、MDA-MB157 Cells、Wayne State University-Head and Neck 13 Cells
PC-3M Cells;背景说明:详见相关文献介绍;传代方法:1:2传代;生长特性:贴壁生长 ;形态特性:详见产品说明;相关产品有:Murine Lung Epithelial-12 Cells、NCIH128 Cells、8226/S Cells
SW 900 Cells;背景说明:详见相关文献介绍;传代方法:1:2-1:3传代;每周换液2-3次。;生长特性:贴壁或悬浮,详见产品说明部分;形态特性:详见产品说明;相关产品有:H295R-S1 Cells、MB39 Cells、Lilly Laboratories Cell-Monkey Kidney 2 Cells
MFE280 Cells;背景说明:详见相关文献介绍;传代方法:1:2传代;生长特性:贴壁生长;形态特性:详见产品说明;相关产品有:EBC1 Cells、3T3-Swiss albino Cells、NPC-TW01 Cells
Highly Aggressively Proliferating Immortalized Cells;背景说明:小胶质细胞;自发永生;Wistar;传代方法:1:2-1:3传代;每周换液2-3次。;生长特性:半贴壁;形态特性:详见产品说明;相关产品有:THP 1 Cells、Anip[973] Cells、H2110 Cells
Y1 Cells;背景说明:详见相关文献介绍;传代方法:1:2-1:3传代;每周换液2-3次。;生长特性:贴壁或悬浮,详见产品说明部分;形态特性:详见产品说明;相关产品有:HeLa-229 Cells、MADISON LUNG TA-109 Cells、SCCVII Cells
GH3 Cells;背景说明:GH3细胞系是由TashjianAH等在1965年7月从一只7月龄的雌性Wistar-Furth大鼠的垂体肿瘤中分离建立的。GH3细胞系不是直接来源于GH1细胞系的克隆,而是从原代培养的GH1细胞在大鼠身上传代两次形成的肿瘤中建立的。上皮样的GH3细胞比GH1分泌更高水平的生长激素,也可产生催乳素。对调控GH3细胞分泌蛋白类激素的研究表明,化可的松可以刺激生长激素的分泌、抑制催乳素的产生。;传代方法:1:2传代;生长特性:疏松贴壁,有漂浮的细胞簇;形态特性:上皮样;相关产品有:Hepatoma 22 Cells、Z-138 Cells、MB-49 Cells
BayGenomics ES cell line RRI375 Cells(拥有STR基因鉴定图谱)
BayGenomics ES cell line XH848 Cells(拥有STR基因鉴定图谱)
F56 [Misidentified human neoplasm] Cells(拥有STR基因鉴定图谱)
ND7/23 Cells(拥有STR基因鉴定图谱)
v6.5 Rbpms-K1 Cells(拥有STR基因鉴定图谱)
MCF-7 A2 Cells(拥有STR基因鉴定图谱)
"
传代方法:1:2-1:4(首次传代建议1:2)
生长特性:贴壁生长
换液频率:每周2-3次
背景资料:详见相关文献介绍
细胞培养实验中常见问题总结:1)一般客户拿到细胞后,应该注意什么?客户收到细胞后先不开盖,放在培养箱静置若干小时后(看细胞密度而定)在倒置显微镜下观察细胞生长情况,并对细胞进行不同倍数拍照(建议受收细胞后观察培养基的颜色和是否有漏情况,显微镜下拍细胞100X,200X各一张),排除细胞本身污染的情况;收到细胞未开封,出现污染状况我们负责免费发送一株细胞。收到细胞时如无异常情况,请在显微镜下观察细胞密度,如为贴壁细胞,未超过80%汇合度时,将培养瓶中培养吸出,留下10ml培养继续培养;超过80%汇合度时,请按细胞培养条件传代培养。如为悬浮细胞,吸出培养、1000转/分钟离心2分钟,吸出上清,管底细胞用新鲜培养基悬浮细胞后移回培养瓶。细胞消化建议使用PBS配制,慎用Hanks配制;2)快递细胞多久能到,是寄冻存的细胞还是复苏HAO的细胞?我们采用快递发货,一般外地2--3天,寄细胞前请确认当地温度,如果气温低于4度的,则采用邮寄冻存细胞;3)可否使用与原先培养条件不同之培养基?不能。每一细胞株均有其定使用且已适应之细胞培养基,若骤然使用和原先提供之培养条件不同之培养基,细胞大都无法立即适应,造成细胞无法存活;4)可否使用与原先培养条件不同之血清种类?不能。血清是细胞培养上一个为重要的营养来源,所以血清的种类和品质对于细胞的生长会产生大的影响。来自不同物种的血清,在一些物质或分子的量或内容物上都有所不同,血清使用错误常会造成细胞无法存活。
H1836 Cells;背景说明:详见相关文献介绍;传代方法:每周换液2-3次。;生长特性:悬浮生长;形态特性:详见产品说明;相关产品有:H-1581 Cells、MUGCHOR1 Cells、GM00215A Cells
FDCP1 Cells;背景说明:详见相关文献介绍;传代方法:2-3天换液1次;生长特性:悬浮生长;形态特性:淋巴母细胞;相关产品有:RT4P Cells、CCRF/CEM Cells、COR-L23 Cells
231-luc Cells;背景说明:详见相关文献介绍;传代方法:1:2传代;生长特性:贴壁或悬浮,详见产品说明部分;形态特性:详见产品说明;相关产品有:BTT739 Cells、HCC-2185 Cells、RPE1-hTERT Cells
┈订┈购┈热┈线:1┈5┈8┈0┈0┈5┈7┈6┈8┈6┈7【微信同号】┈Q┈Q:3┈3┈0┈7┈2┈0┈4┈2┈7┈1;
NCI-H2452[H2452]人间皮瘤传代细胞种子库|送STR图谱
产品包装形式:复苏细胞:T25培养瓶(一瓶)或冻存细胞:1ml冻存管(两支)
来源说明:细胞主要来源ATCC、DSMZ等细胞库
物种来源:Human\Mouse\Rat\Others
IOSE-80 Cells;背景说明:卵巢;上皮细胞;SV40转化;女性;传代方法:1:2-1:3传代;每周换液2-3次。;生长特性:贴壁;形态特性:详见产品说明;相关产品有:mouse Inner Medullary Collecting Duct-3 Cells、LO2 Cells、H1781 Cells
198 Cells(拥有STR基因鉴定图谱)
870 Cells;背景说明:儿童急性髓系白血病;传代方法:1:2-1:3传代;每周换液2-3次。;生长特性:悬浮;形态特性:详见产品说明;相关产品有:H1650 Cells、BTI-Tn5B14 Cells、EFO 27 Cells
OP9 Cells;背景说明:骨髓基质;C57BL/6 x C3H;传代方法:1:2-1:3传代;每周换液2-3次。;生长特性:贴壁;形态特性:详见产品说明;相关产品有:SNU354 Cells、P3X63 Ag8 Cells、HCC-1187 Cells
形态特性:上皮细胞样
NCI-H2452[H2452]人间皮瘤传代细胞种子库|送STR图谱
贴壁细胞(adherent cells):该类细胞的生长必须有可以贴附的支持物表面,细胞依靠自身分泌的或培养基中提供的贴附因子才能在该表面上生长,繁殖;当细胞在该表面生长后,一般形成两种形态,即成纤维样细胞性或上皮样细胞;其生长过程分为游离期、贴壁期、潜伏期、对数期、平台期和衰退期。悬浮细胞(suspension cell):不贴附于生长物,细胞呈圆形,呈单个细胞或者细小细胞团,悬浮细胞生长空间大,传代方便,能够大量增殖。
┈订┈购┈热┈线:1┈5┈8┈0┈0┈5┈7┈6┈8┈6┈7【微信同号】┈Q┈Q:3┈3┈0┈7┈2┈0┈4┈2┈7┈1;
上皮细胞(epithelial cell)是构成上皮组织的基本单位,广泛分布在人体的各个表面和体腔内,外胚层来源:皮肤、腺垂体、内耳膜、角膜、晶状体、鼻腔、口腔、肛门等处的上皮细胞由外胚层发育而来。中胚层来源:间皮、内皮等上皮细胞由中胚层发育而来。内胚层来源:中耳、呼吸道、肺、胸腺、消化道、消化腺、膀胱、阴道、甲状腺、甲状旁腺等处的上皮细胞由内胚层发育而来。许多癌症起源于上皮细胞,如肝细胞癌、结直肠癌、乳腺癌、肺癌、胃癌、前列腺癌、卵巢癌和子宫内膜癌。这些癌症中的上皮细胞通常表现出细胞标志物的变化,如E-cadherin的缺失和N-cadherin、vimentin等间充质细胞标志物的表达上调。
RPMI 8402 Cells;背景说明:急性T淋巴细胞白血病;女性;传代方法:1:2-1:3传代;每周换液2-3次。;生长特性:悬浮;形态特性:详见产品说明;相关产品有:Hs-611-T Cells、AML-2 Cells、HT-1197 Cells
SKLU01 Cells;背景说明:该细胞系源于一位60岁的白人女性患者的肺腺癌组织。;传代方法:1:2传代;每周换液2次。;生长特性:贴壁生长;形态特性:上皮细胞样;相关产品有:WM 239 Cells、MM-1S Cells、ATDC-5 Cells
YAC-1 Cells;背景说明:YAC-1源自Mo-MuLV诱导的A/Sn小鼠淋巴瘤。细胞对NK细胞的作用敏感,可用于NK细胞活性检测。鼠痘病毒阴性。;传代方法:1:2传代;生长特性:悬浮生长;形态特性:淋巴母细胞样;相关产品有:THLE-3 Cells、Hu-P-T3 Cells、THP 1 Cells
SKCol1 Cells;背景说明:该细胞来源于结直肠病人的转移性腹水。;传代方法:1:2-1:3传代,每周2-3次。;生长特性:贴壁生长;形态特性:上皮细胞样;相关产品有:AtT 20 Cells、NCIH250 Cells、OVCAR-8/ADR Cells
EOL1 Cells;背景说明:急性髓系白血病;男性;传代方法:1:2-1:3传代;每周换液2-3次。;生长特性:悬浮;形态特性:详见产品说明;相关产品有:H-2126 Cells、NCI-SNU-475 Cells、CMT.64 Cells
HM Cells;背景说明:小神经胶质 Cells;传代方法:1:2-1:3传代;每周换液2-3次。;生长特性:贴壁;形态特性:详见产品说明;相关产品有:HCC1143 Cells、P388D1 Cells、SK-Mel 1 Cells
SBC-5 Cells;背景说明:详见相关文献介绍;传代方法:每周换液2-3次。;生长特性:贴壁或悬浮,详见产品说明部分;形态特性:详见产品说明;相关产品有:SACC-LM Cells、Soleus clone 8 Cells、253J-Bladder-V Cells
ARO-81 Cells;背景说明:甲状腺癌;女性;传代方法:1:2-1:3传代;每周换液2-3次。;生长特性:贴壁;形态特性:详见产品说明;相关产品有:CT-26 Cells、RCC4 Cells、SK-N-BE(1) Cells
NCIH146 Cells;背景说明:详见相关文献介绍;传代方法:1:2—1:6传代,每周换液2-3次;生长特性:悬浮生长;形态特性:上皮细胞;相关产品有:NCI-H64 Cells、A375SM Cells、293-F Cells
MDAMB468 Cells;背景说明:该细胞是1977年由CailleauR等从一位患有转移性乳腺癌的51岁黑人女性的胸腔积液中分离得到的。虽然供体组织的G6PD等位基因杂合,但此细胞株始终表现为G6PDA表型。P53基因273位密码子存在G→A突变,从而导致Arg→His替代。每个细胞上存在1×106个EGF受体。;传代方法:1:2-1:4传代;2-3天换液1次;生长特性:贴壁生长;形态特性:上皮样;相关产品有:HT1080 Cells、BC-023 Cells、IM9 Cells
Mink Lung Cells;背景说明:详见相关文献介绍;传代方法:1:2-1:3传代;每周换液2-3次。;生长特性:贴壁或悬浮,详见产品说明部分;形态特性:详见产品说明;相关产品有:NCI-H1915 Cells、HCC-44 Cells、LNCaP clone FGC Cells
HRVEC Cells;背景说明:视网膜微血管;内皮 Cells;传代方法:1:2-1:3传代;每周换液2-3次。;生长特性:贴壁;形态特性:详见产品说明;相关产品有:CCK-81 Cells、COLO_320DM Cells、L-6 Cells
HeLa 229 Cells;背景说明:宫颈癌;女性;传代方法:1:2-1:3传代;每周换液2-3次。;生长特性:贴壁;形态特性:详见产品说明;相关产品有:NTERA-2cl.D1 Cells、LS 180 Cells、FRTL5 Cells
GRSL Cells;背景说明:详见相关文献介绍;传代方法:1:2-1:3传代;每周换液2-3次。;生长特性:贴壁或悬浮,详见产品说明部分;形态特性:详见产品说明;相关产品有:Granta519 Cells、DBTRG-05MG Cells、NCI-H1836 Cells
H-1395 Cells;背景说明:详见相关文献介绍;传代方法:1:2传代;5-6天传代一次。;生长特性:贴壁生长;形态特性:上皮样;多角形;相关产品有:A549-Taxol Cells、NCI-322 Cells、UO-31 Cells
DU-145 Cells;背景说明:DU 145 是从一位有3年淋巴细胞白血病史的前列腺癌患者的脑部转移灶中建立的。该细胞系未检测到激素敏感性,酸性酶阳性,单个的细胞可在软琼脂中形成集落。对此细胞和原始肿瘤的亚显微结构分析可见微绒毛、微丝、细胞桥粒、线粒体、发达的高尔基体和异质溶酶体。该细胞不表达前列腺抗原。;传代方法:1:2-1:3传代;每周换液2-3次。;生长特性:贴壁;形态特性:上皮细胞样;相关产品有:HRGEC Cells、Human Pancreatic Duct Epithelial Cells、Hx-147 Cells
DSL-6A-C1 Cells;背景说明:胰腺癌;雄性;Lewis;传代方法:1:2-1:3传代;每周换液2-3次。;生长特性:贴壁;形态特性:详见产品说明;相关产品有:HTh 74 Cells、SW-1271 Cells、HMEC Cells
Abcam A-549 BRD3 KO Cells(拥有STR基因鉴定图谱)
Abcam Raji TAPBP KO Cells(拥有STR基因鉴定图谱)
BayGenomics ES cell line BGB615 Cells(拥有STR基因鉴定图谱)
BayGenomics ES cell line RRS102 Cells(拥有STR基因鉴定图谱)
BayGenomics ES cell line YTA363 Cells(拥有STR基因鉴定图谱)
CHDIi055-A Cells(拥有STR基因鉴定图谱)
DA01870 Cells(拥有STR基因鉴定图谱)
DA05242 Cells(拥有STR基因鉴定图谱)
GE6 Cells(拥有STR基因鉴定图谱)
SW 1271 Cells;背景说明:详见相关文献介绍;传代方法:1:2-1:3传代;每周换液2-3次。;生长特性:贴壁或悬浮,详见产品说明部分;形态特性:详见产品说明;相关产品有:J774 A1 Cells、T-T Cells、COLO-699 Cells
RH-30 Cells;背景说明:肺泡横纹肌肉瘤;骨髓转移;传代方法:1:2-1:3传代;每周换液2-3次。;生长特性:贴壁;形态特性:详见产品说明;相关产品有:IAR-20 Cells、SK-N-BE2C Cells、CMT 93 Cells
Hopkins-92 Cells;背景说明:详见相关文献介绍;传代方法:1:2-1:3传代;每周换液2-3次。;生长特性:贴壁或悬浮,详见产品说明部分;形态特性:详见产品说明;相关产品有:SKBr3 Cells、H1650 Cells、Panc 4.03 Cells
SNU449 Cells;背景说明:详见相关文献介绍;传代方法:1:5-1:10传代;每周2-3次;生长特性:贴壁生长;形态特性:上皮样;多角形;相关产品有:BNL 1MEA.7R.1 Cells、NCI-H1975 Cells、HUC-1 Cells
L929(NCTC) Cells;背景说明:详见相关文献介绍;传代方法:1:2-1:3传代;每周换液2-3次。;生长特性:贴壁或悬浮,详见产品说明部分;形态特性:详见产品说明;相关产品有:C-26 Cells、GP-293 Cells、AHH1 Cells
B-104 Cells;背景说明:神经母细胞瘤;BDIX;传代方法:1:2-1:3传代;每周换液2-3次。;生长特性:贴壁;形态特性:详见产品说明;相关产品有:COLO-320DM Cells、SaOS Cells、RMS 13 Cells
TC-1[JHU-1] Cells;背景说明:详见相关文献介绍;传代方法:1:2传代;生长特性:贴壁生长 ;形态特性:详见产品说明;相关产品有:OCI/AML5 Cells、BEL/FU Cells、MLA 144 Cells
HSC-4 Cells;背景说明:详见相关文献介绍;传代方法:1 x 10^5 cells/10cm dish;生长特性:贴壁生长;形态特性:上皮细胞;相关产品有:RPMC Cells、COLO 679 Cells、SK-N-BE Cells
NCI-446 Cells;背景说明:该细胞是1982年由CarneyD和GazdarAF等从一位小细胞肺癌患者的胸腔积液中建立的。细胞的原始形态并不具有小细胞肺癌特征。这个细胞株是小细胞肺癌的生化和形态学上的变种,表达神经元特有的烯醇酶和脑型肌酸激酶同工酶;左旋多巴脱羧酶、蚕素、抗利尿激素、催产素或胃泌激素释放肽未达到可检测水平。与正常细胞相比,该细胞c-mycDNA序列扩增约20倍,RNA增加15倍。最初传代培养基用含有5%FBS的RPMI1640,另外添加10nM化可的松、0.005mg/ml胰岛素、0.01mg/ml转铁;传代方法:1:2传代;生长特性:贴壁/悬浮生长,混合;形态特性:上皮样;相关产品有:RM1 Cells、H1522 Cells、Intestinal Porcine Epithelial Cell line-1 Cells
COLO-679 Cells;背景说明:详见相关文献介绍;传代方法:1:2传代;生长特性:贴壁生长 ;形态特性:详见产品说明;相关产品有:TE-6 Cells、H283 Cells、3T3-442A Cells
NCI-H1385 Cells;背景说明:详见相关文献介绍;传代方法:1:2-1:3传代;每周换液2-3次。;生长特性:贴壁或悬浮,详见产品说明部分;形态特性:详见产品说明;相关产品有:TCCSUP Cells、H1703 Cells、LYR Cells
NCI-H2452[H2452]人间皮瘤传代细胞种子库|送STR图谱
Mia PACA 2 Cells;背景说明:详见相关文献介绍;传代方法:1:2传代;;生长特性:贴壁生长;形态特性:详见产品说明;相关产品有:U118 Cells、Ramos 1 Cells、GM06141B Cells
JVM3 Cells;背景说明:慢性髓白血病;女性;传代方法:1:2-1:3传代;每周换液2-3次。;生长特性:悬浮;形态特性:详见产品说明;相关产品有:NCI-SNU-761 Cells、MDA-MB-231 Cells、SH-SY5Y Cells
JVM3 Cells;背景说明:慢性髓白血病;女性;传代方法:1:2-1:3传代;每周换液2-3次。;生长特性:悬浮;形态特性:详见产品说明;相关产品有:NCI-SNU-761 Cells、MDA-MB-231 Cells、SH-SY5Y Cells
CA46 Cells;背景说明:该细胞源自Burkitt's淋巴瘤患者的B淋巴细胞,EBNA、Fc阴性。;传代方法:1:2传代;生长特性:悬浮生长;形态特性:淋巴母细胞样;相关产品有:H-69 Cells、C22 (Clara) Cells、Kasumi-6 Cells
GM20018 Cells(拥有STR基因鉴定图谱)
HAP1 IRF3 (-) 2 Cells(拥有STR基因鉴定图谱)
C3H10T1/2 clone8 Cells;背景说明:详见相关文献介绍;传代方法:1:2-1:3传代;每周换液2-3次。;生长特性:贴壁或悬浮,详见产品说明部分;形态特性:详见产品说明;相关产品有:COS-1 Cells、MCF10A Cells、NCIH322 Cells
JROECL19 Cells;背景说明:详见相关文献介绍;传代方法:1:2传代;生长特性:贴壁生长;形态特性:上皮样;相关产品有:LC1/Sq Cells、U118 Cells、BT483 Cells
FU-OV-1 Cells;背景说明:详见相关文献介绍;传代方法:1:2-1:3传代;每周换液2-3次。;生长特性:贴壁或悬浮,详见产品说明部分;形态特性:详见产品说明;相关产品有:NCIH526 Cells、MDA-MB-231-GFP Cells、U-CH1 Cells
UCLA-SO-M20 Cells;背景说明:黑色素瘤;传代方法:1:2-1:3传代;每周换液2-3次。;生长特性:贴壁;形态特性:详见产品说明;相关产品有:HCC-2935 Cells、Henrietta Lacks cells Cells、BC-3H-1 Cells
639V Cells;背景说明:膀胱癌;男性;传代方法:1:2-1:3传代;每周换液2-3次。;生长特性:贴壁;形态特性:详见产品说明;相关产品有:Hs695T Cells、OPM2 Cells、SUDHL-4 Cells
HRVEC Cells;背景说明:视网膜微血管;内皮 Cells;传代方法:1:2-1:3传代;每周换液2-3次。;生长特性:贴壁;形态特性:详见产品说明;相关产品有:CCK-81 Cells、COLO_320DM Cells、L-6 Cells
COLO-205 Cells;背景说明:该细胞系是1957年由T.U.Sample等从患有结肠癌的70岁男性白人的腹水中分离的。该病人在取腹水样品前已用5-尿嘧啶治疗4~6周。角蛋白免疫过氧化物酶染色阳性;产生CEA、IL10。;传代方法:1:2传代;生长特性:贴壁生长;形态特性:上皮样;相关产品有:NCI-H1105 Cells、COV 434 Cells、NMCG-1 Cells
AM Cells;背景说明:详见相关文献介绍;传代方法:1:2传代;生长特性:贴壁生长;形态特性:上皮细胞;相关产品有:HFLS-RA Cells、GLC-15 Cells、HO1N1 Cells
HPS0953 Cells(拥有STR基因鉴定图谱)
Josh 5 Cells(拥有STR基因鉴定图谱)
MDCC-JMV-1 Cells(拥有STR基因鉴定图谱)
ND41865 Cells(拥有STR基因鉴定图谱)
PSFLBV084 Cells(拥有STR基因鉴定图谱)
U2OS GFP-TUBA1B Cells(拥有STR基因鉴定图谱)
UMCGi007-A Cells(拥有STR基因鉴定图谱)
HEV0117 Cells(拥有STR基因鉴定图谱)
Mesothelial cells transfected with pRSV-T 5A Cells;背景说明:详见相关文献介绍;传代方法:1:2传代;生长特性:贴壁生长;形态特性:详见产品说明;相关产品有:H128 Cells、HASMC Cells、NCI-H1299 Cells
COV-362 Cells;背景说明:详见相关文献介绍;传代方法:1:2传代;生长特性:贴壁生长;形态特性:上皮细胞;相关产品有:BAEC Cells、MKN45 Cells、PLB 985 Cells
Det. 562 Cells;背景说明:器官:咽头 疾病:癌 取材转移灶:胸水;传代方法:1:2-1:4传代,2-3天换液1次。;生长特性:贴壁生长;形态特性:上皮细胞;相关产品有:H19-7 Cells、SNU620 Cells、MES 13 Cells
MT-2 Cells;背景说明:详见相关文献介绍;传代方法:1:2-1:3传代;生长特性:悬浮生长;形态特性:淋巴母细胞;相关产品有:Stanford University-Diffuse Histiocytic Lymphoma-16 Cells、SKNO-1 Cells、RPTEC TERT1 Cells
SKMEL2 Cells;背景说明:详见相关文献介绍;传代方法:1:3-1:6传代,2-3天换液1次。;生长特性:贴壁生长;形态特性:多边形的;相关产品有:Tca-83 Cells、SW1353 Cells、GM04679 Cells
SKMEL2 Cells;背景说明:详见相关文献介绍;传代方法:1:3-1:6传代,2-3天换液1次。;生长特性:贴壁生长;形态特性:多边形的;相关产品有:Tca-83 Cells、SW1353 Cells、GM04679 Cells
HCC-94 Cells;背景说明:详见相关文献介绍;传代方法:1:2-1:3传代;每周换液2-3次。;生长特性:贴壁或悬浮,详见产品说明部分;形态特性:详见产品说明;相关产品有:RPE D407 Cells、8226/S Cells、H2081 Cells
TFK-1 Cells;背景说明:胆管癌;男性;传代方法:1:2-1:3传代;每周换液2-3次。;生长特性:贴壁;形态特性:详见产品说明;相关产品有:PNT1A Cells、MES-SA-Dx5 Cells、MDA PCa 2b Cells
OB2 Cells;背景说明:详见相关文献介绍;传代方法:每周2-3次。;生长特性:悬浮生长;形态特性:淋巴母细胞;相关产品有:Lieming Xu-2 Cells、OCI/AML4 Cells、A2780 Cells
SUDHL16 Cells;背景说明:详见相关文献介绍;传代方法:1:2-1:3传代;每周换液2-3次。;生长特性:贴壁或悬浮,详见产品说明部分;形态特性:详见产品说明;相关产品有:NK92-MI Cells、ARO81-1 Cells、NCIH146 Cells
SK-MEL 28 Cells;背景说明:详见相关文献介绍;传代方法:1:3-1:8传代,2-3天换液1次。;生长特性:贴壁生长;形态特性:星形的;相关产品有:NS1-Ag4 Cells、OSC19 Cells、IHC-ST1 Cells
SK-GT-4 Cells;背景说明:详见相关文献介绍;传代方法:1:2-1:3传代;每周换液2-3次。;生长特性:贴壁或悬浮,详见产品说明部分;形态特性:详见产品说明;相关产品有:6-10B Cells、H1963 Cells、M2-10B4 Cells
T. T Cells;背景说明:详见相关文献介绍;传代方法:10^5 cells/60mm dish;生长特性:贴壁生长;形态特性:上皮细胞样;相关产品有:Experimental Mammary Tumour-6 Cells、FDC-P1 Cells、HSC-5 [Human skin squamous cell carcinoma] Cells
NCI-H2452[H2452]人间皮瘤传代细胞种子库|送STR图谱
NPC-TW 039 Cells;背景说明:鼻咽癌;传代方法:1:2-1:3传代;每周换液2-3次。;生长特性:贴壁;形态特性:详见产品说明;相关产品有:Leghorn Male Hepatoma cell line Cells、LLC PK1 Cells、CAL51 Cells
WRL 68 Cells;背景说明:胚胎;肝 Cells;传代方法:1:2-1:3传代;每周换液2-3次。;生长特性:贴壁;形态特性:详见产品说明;相关产品有:RAT2 Cells、LIXC002 Cells、U 138 MG Cells
SN-56/OBR Cells(拥有STR基因鉴定图谱)
SUM-190 Cells;背景说明:乳腺癌;女性;传代方法:1:2-1:3传代;每周换液2-3次。;生长特性:贴壁;形态特性:详见产品说明;相关产品有:NCI-H1355 Cells、FL62891 Cells、Oka-C1 Cells
P3-X63-Ag 8.653 Cells;背景说明:详见相关文献介绍;传代方法:1:2-1:3传代;每周换液2-3次。;生长特性:贴壁或悬浮,详见产品说明部分;形态特性:详见产品说明;相关产品有:NCIH1618 Cells、NBLS Cells、TGW Cells
RM1 Cells;背景说明:前列腺癌;C57BL/6;传代方法:1:2-1:3传代;每周换液2-3次。;生长特性:贴壁;形态特性:详见产品说明;相关产品有:NCIH208 Cells、RAMSCs Cells、CFPAC-1 Cells
M.D. Anderson-Prostate Cancer-2b Cells;背景说明:详见相关文献介绍;传代方法:1:2-1:4传代,2-3天换液1次。;生长特性:贴壁生长;形态特性:上皮细胞;相关产品有:1E8-H Cells、H548 Cells、Panc-03.27 Cells
H-2073 Cells;背景说明:详见相关文献介绍;传代方法:1:3-1:6传代 ;生长特性:贴壁生长;形态特性:上皮细胞;相关产品有:Sf21 Cells、KMB17 Cells、Huh-7 Cells
P3-Jiyoye Cells;背景说明:详见相关文献介绍;传代方法:每周2-3次。;生长特性:悬浮生长;形态特性:淋巴母细胞;相关产品有:M-NFS-60 Cells、SHZ-88 Cells、SK-RC-39 Cells
LIPF178C Cells;背景说明:胆管癌;传代方法:1:2-1:3传代;每周换液2-3次。;生长特性:贴壁;形态特性:详见产品说明;相关产品有:NEC8 Cells、GM04154 Cells、C41 Cells
Normal Rat Kidney-52E Cells;背景说明:详见相关文献介绍;传代方法:1:2传代;生长特性:贴壁生长;形态特性:上皮细胞样;相关产品有:U-138-MG Cells、MDA-MB157 Cells、Wayne State University-Head and Neck 13 Cells
PC-3M Cells;背景说明:详见相关文献介绍;传代方法:1:2传代;生长特性:贴壁生长 ;形态特性:详见产品说明;相关产品有:Murine Lung Epithelial-12 Cells、NCIH128 Cells、8226/S Cells
SW 900 Cells;背景说明:详见相关文献介绍;传代方法:1:2-1:3传代;每周换液2-3次。;生长特性:贴壁或悬浮,详见产品说明部分;形态特性:详见产品说明;相关产品有:H295R-S1 Cells、MB39 Cells、Lilly Laboratories Cell-Monkey Kidney 2 Cells
MFE280 Cells;背景说明:详见相关文献介绍;传代方法:1:2传代;生长特性:贴壁生长;形态特性:详见产品说明;相关产品有:EBC1 Cells、3T3-Swiss albino Cells、NPC-TW01 Cells
Highly Aggressively Proliferating Immortalized Cells;背景说明:小胶质细胞;自发永生;Wistar;传代方法:1:2-1:3传代;每周换液2-3次。;生长特性:半贴壁;形态特性:详见产品说明;相关产品有:THP 1 Cells、Anip[973] Cells、H2110 Cells
Y1 Cells;背景说明:详见相关文献介绍;传代方法:1:2-1:3传代;每周换液2-3次。;生长特性:贴壁或悬浮,详见产品说明部分;形态特性:详见产品说明;相关产品有:HeLa-229 Cells、MADISON LUNG TA-109 Cells、SCCVII Cells
GH3 Cells;背景说明:GH3细胞系是由TashjianAH等在1965年7月从一只7月龄的雌性Wistar-Furth大鼠的垂体肿瘤中分离建立的。GH3细胞系不是直接来源于GH1细胞系的克隆,而是从原代培养的GH1细胞在大鼠身上传代两次形成的肿瘤中建立的。上皮样的GH3细胞比GH1分泌更高水平的生长激素,也可产生催乳素。对调控GH3细胞分泌蛋白类激素的研究表明,化可的松可以刺激生长激素的分泌、抑制催乳素的产生。;传代方法:1:2传代;生长特性:疏松贴壁,有漂浮的细胞簇;形态特性:上皮样;相关产品有:Hepatoma 22 Cells、Z-138 Cells、MB-49 Cells
BayGenomics ES cell line RRI375 Cells(拥有STR基因鉴定图谱)
BayGenomics ES cell line XH848 Cells(拥有STR基因鉴定图谱)
F56 [Misidentified human neoplasm] Cells(拥有STR基因鉴定图谱)
ND7/23 Cells(拥有STR基因鉴定图谱)
v6.5 Rbpms-K1 Cells(拥有STR基因鉴定图谱)
MCF-7 A2 Cells(拥有STR基因鉴定图谱)
"
风险提示:丁香通仅作为第三方平台,为商家信息发布提供平台空间。用户咨询产品时请注意保护个人信息及财产安全,合理判断,谨慎选购商品,商家和用户对交易行为负责。对于医疗器械类产品,请先查证核实企业经营资质和医疗器械产品注册证情况。
文献和实验该产品被引用文献
"PubMed=20164919; DOI=10.1038/nature08768; PMCID=PMC3145113
Bignell G.R., Greenman C.D., Davies H.R., Butler A.P., Edkins S., Andrews J.M., Buck G., Chen L., Beare D., Latimer C., Widaa S., Hinton J., Fahey C., Fu B.-Y., Swamy S., Dalgliesh G.L., Teh B.T., Deloukas P., Yang F.-T., Campbell P.J., Futreal P.A., Stratton M.R.
Signatures of mutation and selection in the cancer genome.
Nature 463:893-898(2010)
PubMed=20215515; DOI=10.1158/0008-5472.CAN-09-3458; PMCID=PMC2881662
Rothenberg S.M., Mohapatra G., Rivera M.N., Winokur D., Greninger P., Nitta M., Sadow P.M., Sooriyakumar G., Brannigan B.W., Ulman M.J., Perera R.M., Wang R., Tam A., Ma X.-J., Erlander M., Sgroi D.C., Rocco J.W., Lingen M.W., Cohen E.E.W., Louis D.N., Settleman J., Haber D.A.
A genome-wide screen for microdeletions reveals disruption of polarity complex genes in diverse human cancers.
Cancer Res. 70:2158-2164(2010)
PubMed=21245096; DOI=10.1158/0008-5472.CAN-10-2164
Murakami H., Mizuno T., Taniguchi T., Fujii M., Ishiguro F., Fukui T., Akatsuka S., Horio Y., Hida T., Kondo Y., Toyokuni S., Osada H., Sekido Y.
LATS2 is a tumor suppressor gene of malignant mesothelioma.
Cancer Res. 71:873-883(2011)
PubMed=21642991; DOI=10.1038/ng.855; PMCID=PMC4643098
Bott M.J., Brevet M., Taylor B.S., Shimizu S., Ito T., Wang L., Creaney J., Lake R.A., Zakowski M.F., Reva B., Sander C., Delsite R., Powell S.N., Zhou Q., Shen R.-L., Olshen A.B., Rusch V.W., Ladanyi M.
The nuclear deubiquitinase BAP1 is commonly inactivated by somatic mutations and 3p21.1 losses in malignant pleural mesothelioma.
Nat. Genet. 43:668-672(2011)
PubMed=22460905; DOI=10.1038/nature11003; PMCID=PMC3320027
Barretina J.G., Caponigro G., Stransky N., Venkatesan K., Margolin A.A., Kim S., Wilson C.J., Lehar J., Kryukov G.V., Sonkin D., Reddy A., Liu M., Murray L., Berger M.F., Monahan J.E., Morais P., Meltzer J., Korejwa A., Jane-Valbuena J., Mapa F.A., Thibault J., Bric-Furlong E., Raman P., Shipway A., Engels I.H., Cheng J., Yu G.-Y.K., Yu J.-J., Aspesi P. Jr., de Silva M., Jagtap K., Jones M.D., Wang L., Hatton C., Palescandolo E., Gupta S., Mahan S., Sougnez C., Onofrio R.C., Liefeld T., MacConaill L.E., Winckler W., Reich M., Li N.-X., Mesirov J.P., Gabriel S.B., Getz G., Ardlie K., Chan V., Myer V.E., Weber B.L., Porter J., Warmuth M., Finan P., Harris J.L., Meyerson M.L., Golub T.R., Morrissey M.P., Sellers W.R., Schlegel R., Garraway L.A.
The Cancer Cell Line Encyclopedia enables predictive modelling of anticancer drug sensitivity.
Nature 483:603-607(2012)
PubMed=24926545; DOI=10.1097/JTO.0000000000000202; PMCID=PMC4287384
Riquelme E., Suraokar M.B., Rodriguez J., Mino B., Lin H.Y., Rice D.C., Tsao A., Wistuba I.I.
Frequent coamplification and cooperation between C-MYC and PVT1 oncogenes promote malignant pleural mesothelioma.
J. Thorac. Oncol. 9:998-1007(2014)
PubMed=25984343; DOI=10.1038/sdata.2014.35; PMCID=PMC4432652
Cowley G.S., Weir B.A., Vazquez F., Tamayo P., Scott J.A., Rusin S., East-Seletsky A., Ali L.D., Gerath W.F.J., Pantel S.E., Lizotte P.H., Jiang G.-Z., Hsiao J., Tsherniak A., Dwinell E., Aoyama S., Okamoto M., Harrington W., Gelfand E.T., Green T.M., Tomko M.J., Gopal S., Wong T.C., Li H.-B., Howell S., Stransky N., Liefeld T., Jang D., Bistline J., Meyers B.H., Armstrong S.A., Anderson K.C., Stegmaier K., Reich M., Pellman D., Boehm J.S., Mesirov J.P., Golub T.R., Root D.E., Hahn W.C.
Parallel genome-scale loss of function screens in 216 cancer cell lines for the identification of context-specific genetic dependencies.
Sci. Data 1:140035-140035(2014)
PubMed=25485619; DOI=10.1038/nbt.3080
Klijn C., Durinck S., Stawiski E.W., Haverty P.M., Jiang Z.-S., Liu H.-B., Degenhardt J., Mayba O., Gnad F., Liu J.-F., Pau G., Reeder J., Cao Y., Mukhyala K., Selvaraj S.K., Yu M.-M., Zynda G.J., Brauer M.J., Wu T.D., Gentleman R.C., Manning G., Yauch R.L., Bourgon R., Stokoe D., Modrusan Z., Neve R.M., de Sauvage F.J., Settleman J., Seshagiri S., Zhang Z.-M.
A comprehensive transcriptional portrait of human cancer cell lines.
Nat. Biotechnol. 33:306-312(2015)
PubMed=25877200; DOI=10.1038/nature14397
Yu M., Selvaraj S.K., Liang-Chu M.M.Y., Aghajani S., Busse M., Yuan J., Lee G., Peale F.V., Klijn C., Bourgon R., Kaminker J.S., Neve R.M.
A resource for cell line authentication, annotation and quality control.
Nature 520:307-311(2015)
PubMed=25902174; DOI=10.1097/JTO.0000000000000493
Miyanaga A., Masuda M., Tsuta K., Kawasaki K., Nakamura Y., Sakuma T., Asamura H., Gemma A., Yamada T.
Hippo pathway gene mutations in malignant mesothelioma: revealed by RNA and targeted exon sequencing.
J. Thorac. Oncol. 10:844-851(2015)
PubMed=26011428; DOI=10.1111/cas.12698; PMCID=PMC4556387
Hakiri S., Osada H., Ishiguro F., Murakami H., Murakami-Tonami Y., Yokoi K., Sekido Y.
Functional differences between wild-type and mutant-type BRCA1-associated protein 1 tumor suppressor against malignant mesothelioma cells.
Cancer Sci. 106:990-999(2015)
PubMed=26589293; DOI=10.1186/s13073-015-0240-5; PMCID=PMC4653878
Scholtalbers J., Boegel S., Bukur T., Byl M., Goerges S., Sorn P., Loewer M., Sahin U., Castle J.C.
TCLP: an online cancer cell line catalogue integrating HLA type, predicted neo-epitopes, virus and gene expression.
Genome Med. 7:118.1-118.7(2015)
PubMed=27397505; DOI=10.1016/j.cell.2016.06.017; PMCID=PMC4967469
Iorio F., Knijnenburg T.A., Vis D.J., Bignell G.R., Menden M.P., Schubert M., Aben N., Goncalves E., Barthorpe S., Lightfoot H., Cokelaer T., Greninger P., van Dyk E., Chang H., de Silva H., Heyn H., Deng X.-M., Egan R.K., Liu Q.-S., Miroo T., Mitropoulos X., Richardson L., Wang J.-H., Zhang T.-H., Moran S., Sayols S., Soleimani M., Tamborero D., Lopez-Bigas N., Ross-Macdonald P., Esteller M., Gray N.S., Haber D.A., Stratton M.R., Benes C.H., Wessels L.F.A., Saez-Rodriguez J., McDermott U., Garnett M.J.
A landscape of pharmacogenomic interactions in cancer.
Cell 166:740-754(2016)
PubMed=28553954; DOI=10.1038/onc.2017.147
Kato T., Sato T., Yokoi K., Sekido Y.
E-cadherin expression is correlated with focal adhesion kinase inhibitor resistance in merlin-negative malignant mesothelioma cells.
Oncogene 36:5522-5531(2017)
PubMed=29681454; DOI=10.1016/j.cell.2018.03.028; PMCID=PMC5935540
McMillan E.A., Ryu M.-J., Diep C.H., Mendiratta S., Clemenceau J.R., Vaden R.M., Kim J.-H., Motoyaji T., Covington K.R., Peyton M., Huffman K., Wu X.-F., Girard L., Sung Y., Chen P.-H., Mallipeddi P.L., Lee J.Y., Hanson J., Voruganti S., Yu Y., Park S., Sudderth J., DeSevo C., Muzny D.M., Doddapaneni H., Gazdar A.F., Gibbs R.A., Hwang T.H., Heymach J.V., Wistuba I.I., Coombes K.R., Williams N.S., Wheeler D.A., MacMillan J.B., DeBerardinis R.J., Roth M.G., Posner B.A., Minna J.D., Kim H.S., White M.A.
Chemistry-first approach for nomination of personalized treatment in lung cancer.
Cell 173:864-878.e29(2018)
PubMed=30894373; DOI=10.1158/0008-5472.CAN-18-2747; PMCID=PMC6445675
Dutil J., Chen Z.-H., Monteiro A.N.A., Teer J.K., Eschrich S.A.
An interactive resource to probe genetic diversity and estimated ancestry in cancer cell lines.
Cancer Res. 79:1263-1273(2019)
PubMed=31068700; DOI=10.1038/s41586-019-1186-3; PMCID=PMC6697103
Ghandi M., Huang F.W., Jane-Valbuena J., Kryukov G.V., Lo C.C., McDonald E.R. 3rd, Barretina J.G., Gelfand E.T., Bielski C.M., Li H.-X., Hu K., Andreev-Drakhlin A.Y., Kim J., Hess J.M., Haas B.J., Aguet F., Weir B.A., Rothberg M.V., Paolella B.R., Lawrence M.S., Akbani R., Lu Y.-L., Tiv H.L., Gokhale P.C., de Weck A., Mansour A.A., Oh C., Shih J., Hadi K., Rosen Y., Bistline J., Venkatesan K., Reddy A., Sonkin D., Liu M., Lehar J., Korn J.M., Porter D.A., Jones M.D., Golji J., Caponigro G., Taylor J.E., Dunning C.M., Creech A.L., Warren A.C., McFarland J.M., Zamanighomi M., Kauffmann A., Stransky N., Imielinski M., Maruvka Y.E., Cherniack A.D., Tsherniak A., Vazquez F., Jaffe J.D., Lane A.A., Weinstock D.M., Johannessen C.M., Morrissey M.P., Stegmeier F., Schlegel R., Hahn W.C., Getz G., Mills G.B., Boehm J.S., Golub T.R., Garraway L.A., Sellers W.R.
Next-generation characterization of the Cancer Cell Line Encyclopedia.
Nature 569:503-508(2019)"
Bignell G.R., Greenman C.D., Davies H.R., Butler A.P., Edkins S., Andrews J.M., Buck G., Chen L., Beare D., Latimer C., Widaa S., Hinton J., Fahey C., Fu B.-Y., Swamy S., Dalgliesh G.L., Teh B.T., Deloukas P., Yang F.-T., Campbell P.J., Futreal P.A., Stratton M.R.
Signatures of mutation and selection in the cancer genome.
Nature 463:893-898(2010)
PubMed=20215515; DOI=10.1158/0008-5472.CAN-09-3458; PMCID=PMC2881662
Rothenberg S.M., Mohapatra G., Rivera M.N., Winokur D., Greninger P., Nitta M., Sadow P.M., Sooriyakumar G., Brannigan B.W., Ulman M.J., Perera R.M., Wang R., Tam A., Ma X.-J., Erlander M., Sgroi D.C., Rocco J.W., Lingen M.W., Cohen E.E.W., Louis D.N., Settleman J., Haber D.A.
A genome-wide screen for microdeletions reveals disruption of polarity complex genes in diverse human cancers.
Cancer Res. 70:2158-2164(2010)
PubMed=21245096; DOI=10.1158/0008-5472.CAN-10-2164
Murakami H., Mizuno T., Taniguchi T., Fujii M., Ishiguro F., Fukui T., Akatsuka S., Horio Y., Hida T., Kondo Y., Toyokuni S., Osada H., Sekido Y.
LATS2 is a tumor suppressor gene of malignant mesothelioma.
Cancer Res. 71:873-883(2011)
PubMed=21642991; DOI=10.1038/ng.855; PMCID=PMC4643098
Bott M.J., Brevet M., Taylor B.S., Shimizu S., Ito T., Wang L., Creaney J., Lake R.A., Zakowski M.F., Reva B., Sander C., Delsite R., Powell S.N., Zhou Q., Shen R.-L., Olshen A.B., Rusch V.W., Ladanyi M.
The nuclear deubiquitinase BAP1 is commonly inactivated by somatic mutations and 3p21.1 losses in malignant pleural mesothelioma.
Nat. Genet. 43:668-672(2011)
PubMed=22460905; DOI=10.1038/nature11003; PMCID=PMC3320027
Barretina J.G., Caponigro G., Stransky N., Venkatesan K., Margolin A.A., Kim S., Wilson C.J., Lehar J., Kryukov G.V., Sonkin D., Reddy A., Liu M., Murray L., Berger M.F., Monahan J.E., Morais P., Meltzer J., Korejwa A., Jane-Valbuena J., Mapa F.A., Thibault J., Bric-Furlong E., Raman P., Shipway A., Engels I.H., Cheng J., Yu G.-Y.K., Yu J.-J., Aspesi P. Jr., de Silva M., Jagtap K., Jones M.D., Wang L., Hatton C., Palescandolo E., Gupta S., Mahan S., Sougnez C., Onofrio R.C., Liefeld T., MacConaill L.E., Winckler W., Reich M., Li N.-X., Mesirov J.P., Gabriel S.B., Getz G., Ardlie K., Chan V., Myer V.E., Weber B.L., Porter J., Warmuth M., Finan P., Harris J.L., Meyerson M.L., Golub T.R., Morrissey M.P., Sellers W.R., Schlegel R., Garraway L.A.
The Cancer Cell Line Encyclopedia enables predictive modelling of anticancer drug sensitivity.
Nature 483:603-607(2012)
PubMed=24926545; DOI=10.1097/JTO.0000000000000202; PMCID=PMC4287384
Riquelme E., Suraokar M.B., Rodriguez J., Mino B., Lin H.Y., Rice D.C., Tsao A., Wistuba I.I.
Frequent coamplification and cooperation between C-MYC and PVT1 oncogenes promote malignant pleural mesothelioma.
J. Thorac. Oncol. 9:998-1007(2014)
PubMed=25984343; DOI=10.1038/sdata.2014.35; PMCID=PMC4432652
Cowley G.S., Weir B.A., Vazquez F., Tamayo P., Scott J.A., Rusin S., East-Seletsky A., Ali L.D., Gerath W.F.J., Pantel S.E., Lizotte P.H., Jiang G.-Z., Hsiao J., Tsherniak A., Dwinell E., Aoyama S., Okamoto M., Harrington W., Gelfand E.T., Green T.M., Tomko M.J., Gopal S., Wong T.C., Li H.-B., Howell S., Stransky N., Liefeld T., Jang D., Bistline J., Meyers B.H., Armstrong S.A., Anderson K.C., Stegmaier K., Reich M., Pellman D., Boehm J.S., Mesirov J.P., Golub T.R., Root D.E., Hahn W.C.
Parallel genome-scale loss of function screens in 216 cancer cell lines for the identification of context-specific genetic dependencies.
Sci. Data 1:140035-140035(2014)
PubMed=25485619; DOI=10.1038/nbt.3080
Klijn C., Durinck S., Stawiski E.W., Haverty P.M., Jiang Z.-S., Liu H.-B., Degenhardt J., Mayba O., Gnad F., Liu J.-F., Pau G., Reeder J., Cao Y., Mukhyala K., Selvaraj S.K., Yu M.-M., Zynda G.J., Brauer M.J., Wu T.D., Gentleman R.C., Manning G., Yauch R.L., Bourgon R., Stokoe D., Modrusan Z., Neve R.M., de Sauvage F.J., Settleman J., Seshagiri S., Zhang Z.-M.
A comprehensive transcriptional portrait of human cancer cell lines.
Nat. Biotechnol. 33:306-312(2015)
PubMed=25877200; DOI=10.1038/nature14397
Yu M., Selvaraj S.K., Liang-Chu M.M.Y., Aghajani S., Busse M., Yuan J., Lee G., Peale F.V., Klijn C., Bourgon R., Kaminker J.S., Neve R.M.
A resource for cell line authentication, annotation and quality control.
Nature 520:307-311(2015)
PubMed=25902174; DOI=10.1097/JTO.0000000000000493
Miyanaga A., Masuda M., Tsuta K., Kawasaki K., Nakamura Y., Sakuma T., Asamura H., Gemma A., Yamada T.
Hippo pathway gene mutations in malignant mesothelioma: revealed by RNA and targeted exon sequencing.
J. Thorac. Oncol. 10:844-851(2015)
PubMed=26011428; DOI=10.1111/cas.12698; PMCID=PMC4556387
Hakiri S., Osada H., Ishiguro F., Murakami H., Murakami-Tonami Y., Yokoi K., Sekido Y.
Functional differences between wild-type and mutant-type BRCA1-associated protein 1 tumor suppressor against malignant mesothelioma cells.
Cancer Sci. 106:990-999(2015)
PubMed=26589293; DOI=10.1186/s13073-015-0240-5; PMCID=PMC4653878
Scholtalbers J., Boegel S., Bukur T., Byl M., Goerges S., Sorn P., Loewer M., Sahin U., Castle J.C.
TCLP: an online cancer cell line catalogue integrating HLA type, predicted neo-epitopes, virus and gene expression.
Genome Med. 7:118.1-118.7(2015)
PubMed=27397505; DOI=10.1016/j.cell.2016.06.017; PMCID=PMC4967469
Iorio F., Knijnenburg T.A., Vis D.J., Bignell G.R., Menden M.P., Schubert M., Aben N., Goncalves E., Barthorpe S., Lightfoot H., Cokelaer T., Greninger P., van Dyk E., Chang H., de Silva H., Heyn H., Deng X.-M., Egan R.K., Liu Q.-S., Miroo T., Mitropoulos X., Richardson L., Wang J.-H., Zhang T.-H., Moran S., Sayols S., Soleimani M., Tamborero D., Lopez-Bigas N., Ross-Macdonald P., Esteller M., Gray N.S., Haber D.A., Stratton M.R., Benes C.H., Wessels L.F.A., Saez-Rodriguez J., McDermott U., Garnett M.J.
A landscape of pharmacogenomic interactions in cancer.
Cell 166:740-754(2016)
PubMed=28553954; DOI=10.1038/onc.2017.147
Kato T., Sato T., Yokoi K., Sekido Y.
E-cadherin expression is correlated with focal adhesion kinase inhibitor resistance in merlin-negative malignant mesothelioma cells.
Oncogene 36:5522-5531(2017)
PubMed=29681454; DOI=10.1016/j.cell.2018.03.028; PMCID=PMC5935540
McMillan E.A., Ryu M.-J., Diep C.H., Mendiratta S., Clemenceau J.R., Vaden R.M., Kim J.-H., Motoyaji T., Covington K.R., Peyton M., Huffman K., Wu X.-F., Girard L., Sung Y., Chen P.-H., Mallipeddi P.L., Lee J.Y., Hanson J., Voruganti S., Yu Y., Park S., Sudderth J., DeSevo C., Muzny D.M., Doddapaneni H., Gazdar A.F., Gibbs R.A., Hwang T.H., Heymach J.V., Wistuba I.I., Coombes K.R., Williams N.S., Wheeler D.A., MacMillan J.B., DeBerardinis R.J., Roth M.G., Posner B.A., Minna J.D., Kim H.S., White M.A.
Chemistry-first approach for nomination of personalized treatment in lung cancer.
Cell 173:864-878.e29(2018)
PubMed=30894373; DOI=10.1158/0008-5472.CAN-18-2747; PMCID=PMC6445675
Dutil J., Chen Z.-H., Monteiro A.N.A., Teer J.K., Eschrich S.A.
An interactive resource to probe genetic diversity and estimated ancestry in cancer cell lines.
Cancer Res. 79:1263-1273(2019)
PubMed=31068700; DOI=10.1038/s41586-019-1186-3; PMCID=PMC6697103
Ghandi M., Huang F.W., Jane-Valbuena J., Kryukov G.V., Lo C.C., McDonald E.R. 3rd, Barretina J.G., Gelfand E.T., Bielski C.M., Li H.-X., Hu K., Andreev-Drakhlin A.Y., Kim J., Hess J.M., Haas B.J., Aguet F., Weir B.A., Rothberg M.V., Paolella B.R., Lawrence M.S., Akbani R., Lu Y.-L., Tiv H.L., Gokhale P.C., de Weck A., Mansour A.A., Oh C., Shih J., Hadi K., Rosen Y., Bistline J., Venkatesan K., Reddy A., Sonkin D., Liu M., Lehar J., Korn J.M., Porter D.A., Jones M.D., Golji J., Caponigro G., Taylor J.E., Dunning C.M., Creech A.L., Warren A.C., McFarland J.M., Zamanighomi M., Kauffmann A., Stransky N., Imielinski M., Maruvka Y.E., Cherniack A.D., Tsherniak A., Vazquez F., Jaffe J.D., Lane A.A., Weinstock D.M., Johannessen C.M., Morrissey M.P., Stegmeier F., Schlegel R., Hahn W.C., Getz G., Mills G.B., Boehm J.S., Golub T.R., Garraway L.A., Sellers W.R.
Next-generation characterization of the Cancer Cell Line Encyclopedia.
Nature 569:503-508(2019)"
文献支持
NCI-H2452[H2452]人间皮瘤传代细胞种子库|送STR图谱
¥850 - 2150


![NCI-H2452[H2452]人间皮瘤传代细胞种子库|送STR图谱](https://img1.dxycdn.com/p/s14/2025/0211/860/0637440339707129881.jpg)